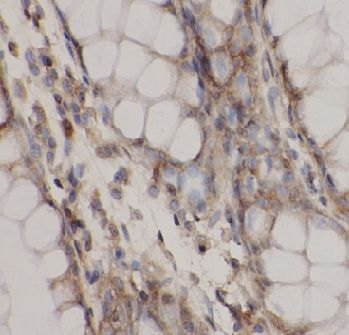

anti- TNFRSF6B antibodyСпецификация| Highlight | New Arrivals -2022 | | Clonality | polyclonal | | Host | Rabbit | | Specificity | Human | | Tested Application | ELISA, IHC | | Delivery Time | 2 to 4 working days | | Isotype | IgG | | Form | liquid | | Purification | Immunogen affinity purified | | Purity | ≥95% as determined by SDS-PAGE | | Uniprot ID | O95407 | | Gene ID | | | Ссылка на страницу на сайте производителя | ссылка | | Инструкция | PDF | | Storage | PBS with 0.02% sodium azide and 50% glycerol pH 7.3,-20℃ for 12 months(Avoid repeated freeze / thaw cycles.) | | Background | Decoy receptor that can neutralize the cytotoxic ligands TNFS14/LIGHT, TNFSF15 and TNFSF6/FASL. Protects against apoptosis. | | Immunogen | tumor necrosis factor receptor superfamily, member 6b, decoy | | Synonyms | DCR3, Decoy receptor 3, Decoy receptor for Fas ligand, M68, TNFRSF6B, TR6, TNF6B | | Recommended dilution | IHC: 1:50-1:500 | | | |
Информация для заказа| Область использования: | Производство: | Fine Biotech | | Метод: | Антитела | | Объем: | 100µg | | Кат. номер: | FNab10343 | | Цена (с НДС 20%): | по запросу | В корзину  | Наименование: anti- TNFRSF6B antibody. Наименование: anti- TNFRSF6B antibody.
Примечание: |
|
